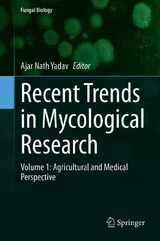
Recent Trends in Mycological Research -

Fungi range from being microscopic, single-celled yeasts to multicellular and heterotrophic in nature. Fungal communities have been found in vast ranges of environmental conditions. They can be associated with plants epiphytically, endophytically, or rhizospherically. Extreme environments represent unique ecosystems that harbor novel biodiversity of fungal communities.
Interest in the exploration of fungal diversity has been spurred by the fact that fungi perform numerous functions integral in sustaining the biosphere, ranging from nutrient cycling to environmental detoxification, which involves processes like augmentation, supplementation, and recycling of plant nutrients - a particularly important process in sustainable agriculture. Fungal communities from natural and extreme habitats help promote plant growth, enhance crop yield, and enhance soil fertility via direct or indirect plant growth promoting (PGP) mechanisms of solubilization of phosphorus, potassium, and zinc, production of ammonia, hydrogen cyanides, phytohormones, Fe-chelating compounds, extracellular hydrolytic enzymes, and bioactive secondary metabolites. These PGP fungi could be used as biofertilizers, bioinoculants, and biocontrol agents in place of chemical fertilizers and pesticides in eco-friendly manners for sustainable agriculture and environments.
Along with agricultural applications, medically important fungi play a significant role for human health. Fungal communities are useful for sustainable environments as they are used for bioremediation which is the use of microorganisms' metabolism to degrade waste contaminants (sewage, domestic, and industrial effluents) into non-toxic or less toxic materials by natural biological processes. Fungi could be used as mycoremediation for the future of environmental sustainability. Fungi and fungal products have the biochemical and ecological capability to degrade environmental organic chemicals and to decrease the risk associated with metals, semi-metals, and noble metals either by chemical modification or by manipulating chemical bioavailability.
The two volumes of Recent Trends in Mycological Research aim to provide an understanding of fungal communities from diverse environmental habitats and their potential applications in agriculture, medical, environments and industry. The books are useful to scientists, researchers, and students involved in microbiology, biotechnology, agriculture, molecular biology, environmental biology and related subjects.
Ajar Nath Yadav is an Assistant Professor (Senior Scale) in Department of Biotechnology, Dr. Khem Singh Gill Akal College of Agriculture, Eternal University, Baru Sahib, Himachal Pradesh, India. He has 5 years of teaching and 11 years of research experiences in the field of Microbial Biotechnology, Microbial Diversity, and Plant-Microbe-Interactions. Dr. Yadav obtained doctorate in Microbial Biotechnology, jointly from ICAR-Indian Agricultural research Institute (IARI), New Delhi and Birla Institute of Technology, Mesra, Ranchi, India; M.Sc. (Biotechnology) from Bundelkhand University and B.Sc. (CBZ) from the University of Allahabad, India. Dr. Yadav has 297 publications, with
h-index of 42,
i10-index of 96, and 4238 citations (Google Scholar).
Dr. Yadav is editor of 11 Springer-Nature, 05 CRC Press Taylor & Francis and 02 Elsevier books. Dr. Yadav has got 12 Best Paper Presentation Awards, and 01 Young Scientist Award (NASI-Swarna Jayanti Purskar). Dr. Yadav received 'Outstanding Teacher Award' in 6
th Annual Convocation 2018 by Eternal University, Baru Sahib, Himachal Pradesh. Dr. Yadav has a long-standing interest in teaching at the UG, PG and PhD level and is involved in taking courses in microbiology, and microbial biotechnology. Dr. Yadav is currently handling two projects one funded by Department of Environments, Science & Technology (DEST), Shimla and one by HP Council for Science, Technology & Environment (HIMCOSTE). Dr. Yadav has guided 01 Ph.D. and 01 M.Sc. Scholar and presently he is guiding 05 scholars for PhD degree. In his credit -6700 microbes (Archaea, bacteria and fungi) isolated from diverse sources and -550 potential and efficient microbes deposited at culture collection ICAR-National Bureau of Agriculturally Important Microorganisms (NBAIM), Mau, Uttar Pradesh, India. He has deposited
2423 nucleotide sequences and
03 whole genome sequences (
Bacillus thuringiensis AKS47,
Arthrobacter agilis L77 and
Halolamina pelagica CDK2) and
02 transcriptome to NCBI GenBank databases: in public domain. The niche-specific microbes from extreme environments were reported as specific bio-inoculants (Biofertilizers) for crops growing in normal and diverse abiotic stress conditions. Dr. Yadav and group have developed technology for screening of archaea for phosphorus solubilization for the first time. He has been serving as an editor/editorial board member and reviewer for different national and international peer-reviewed journals. He has lifetime membership of Association of Microbiologist in India, and Indian Science Congress Council, India.